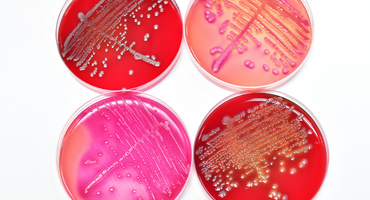

מרפאות ילדים - אשפוז יום ילדים
היחידה לאשפוז יום ומרפאות ילדים במרכז הרפואי שמיר (אסף הרופא), מרכזת את השירות האמבולטורי של חטיבת הילדים ומטפלת מדי שנה בלמעלה מ-12,000 ילדים. היחידה מעניקה שירותי רפואת ילדים בכל התחומים, למטופלים שבעיותיהם הרפואיות אינן ניתנות לבירור או לטיפול בקהילה, וגם למטופלים שאינם נזקקים לאשפוז מלא, אך זקוקים לטיפולים ולבדיקות; מהם בהרדמה, בהרגעה, או לשם מתן תרופות בהשגחה רפואית וסיעודית, שלאחריהן ניתן יהיה לשחרר אותם לבתיהם.
טיפולים ופרוצדורות
לצורך טיפול ביחידה, יש להביא הפניה מרופא והתחייבות מתאימה מקופת החולים.
מידע להורים
-

היחידה להפרעות אכילה בילדים ומתבגרים
המודעות למגוון הבעיות הרחב המאפיין את הפרעות האכילה, לצד הביקוש הגובר לטיפול בהן, איפשרו הקמת שירות ייחודי בנושא חשוב זה.
-

התפתחות הילד ומשפחתו - מכון
המכון להתפתחות הילד ומשפחתו מיועד לבדיקה אבחון וטיפול במגוון בעיות התפתחותיות בילדים החל מגיל ינקות. מכוננו נוסד ב-1972 והינו אחד המכונים הוותיקים בישראל. המכון מוכר על ידי משרד הבריאות והמוסדות האקדמיים להכשרה מקצועית.
-

המכון לאנדוקרינולוגיה וסוכרת ילדים ונוער
המכון נותן מענה אבחוני וטיפולי, רפואי ופרא-רפואי, מקצועי, יסודי, מקיף ומכיל לילדים ונוער עם הפרעות הורמונאליות , ולבני משפחותיהם, תוך התייחסות לתא המשפחתי כתא מטפל ומביא לשינוי.
-

אורולוגיית ילדים
התחום האורולוגי הולך ומתרחב ומספק מענה למצבים המחייבים ניתוחים בגיל הילדות, מתגלים לעיתים כבר באבחון טרום לידתי בבדיקת סקירת מערכות, לעיתים סמוך מאוד לאחר הלידה ולעיתים בגיל ילדות מאוחר יותר ואף בבני נוער.
-

מרפאה המטולוגית לילדים
מרפאת המטולוגיית לילדים/ות - נערים/ות, מספקת יעוץ המטולוגי בשל הפרעה בספירות דם, חשד לבעיית קרישה או דמם, ומגוון בעיות אחרות המשפיעות על תאי הדם.
-
מחלות זיהומיות בקרב ילדים
המרפאה למחלות זיהומיות בילדים במרכז הרפואי, מייעץ לאגפים השונים של חטיבת הילדים: מחלקת האשפוז ב', היחידה לטיפול נמרץ בילדים, מחלקת יילודים והיחידה לטיפול מיוחד ביילוד ובפג, מחלקת כירורגית ילדים והמחלקה לנוירולוגיה של הילד ושיקומו.
-

מרפאת גפן – גוף נפש
המרפאה מיועדת לילדים ונוער (גיל 6 עד 18) ובני משפחותיהם, עם תופעות גופניות אשר אינן מוסברות באופן מלא על ידי גורמים רפואיים ראשוניים.
-

מרפאת מעקב לילדים
מרפאת מעקב הינה נותנת מענה לילדים שאושפזו במחלקת הילדים לשם השלמת טיפול, בירור ו/או מתן תשובות מעבדה ובדיקות דימות שבוצעו בבית החולים.
-

נוירולוגיה ילדים - מרפאות
המרפאות הנוירולוגיות מהוות מסגרת ייחודית לאבחון מעקב וטיפול לילדים ומתבגרים עם מגוון רחב של בעיות נוירולוגיות כגון נוירולוגיה של הילוד, אפילפסיה, דאטה קטוגנית וקוצב וגאלי, הפרעות נוירומוטוריות, כאבי ראש, מיגרנות ופסוידוטומור, מחלות נוירולוגיות אימונולוגיות, עיוותים במבנה הגולגולת, היקף ראש גדול או קטן, מחלות נוירולוגיות נדירות ועוד.
-

נפרולוגיה ילדים
היחידה לנפרולוגיה ילדים במרכז הרפואי מלווה ילדים ומתבגרים עם מגוון מחלות כליה ודרכי שתן החל מהשלב הטרום לידתי ועד לבגרות, ומייעצת למחלקות האשפוז, למיון ולמרפאות המומחים השונות.
-

קרדיולוגיה ילדים - מרפאה
המרפאה מטפלת ביילודים, ילדים ונוער, המאובחנים עם מום לבבי מולד. החולים עוברים עיבוד קליני, וכן מבוצעות בדיקות אקו-לב, הולטר וארגומטריה, עפ"י הצרכים הקליניים.
-

מרפאה ראומטולוגית ילדים
המרפאה לראומטולוגית ילדים במרכז הרפואי שמיר (אסף הרופא) מנוהלת בידי ד"ר מיכל פלדון, ומטפלת בילדים עם מחלות דלקתיות שונות כולל דלקת פרקים של ילדות, לופוס (זאבת), קדחת ים תיכונית ו pfapa, מחלות כלי דם כמו קואסקי והנוך שונליין פורפורה, מחלות דלקתיות של עיניים, עור ושריר ובתסמונות כאב כרוניות.
ציוד ומתקנים
היחידה לפדיאטריה אמבולטורית שוכנת במבנה נאה, מרווח ומשופץ, מוקף גינה מטופחת, המשרה על הבאים אליו אווירה של רוגע ושקט. למטופלים ובני משפחתם, יש פינות המתנה, חלקן עם מחשבים וטלוויזיה, כאשר לרשות המאושפזים עומדים חדרי פעילות מיוחדים.
הצוות
רופאי היחידה מטפלים ומעניקים ייעוץ והדרכה גם במרפאות בקהילה, ביחידות לאשפוז יום, בקהילה ובבתי הספר. בין השאר, הם מובילים פרויקט הדרכה וסדנאות בשיתוף עיריית ראשון לציון ובבתי ספר תיכוניים בעיר - בנושא: "הבעיות הרפואיות של גיל ההתבגרות".
היחידה גם מפעילה מרפאת ילדים בשכונת גן חק"ל, הנמצאת בין רמלה ללוד. במרפאה ניתנים שירותים מיוחדים לילדים ערבים, תושבי רמלה - לוד, בידי רופאי ילדים מומחים.